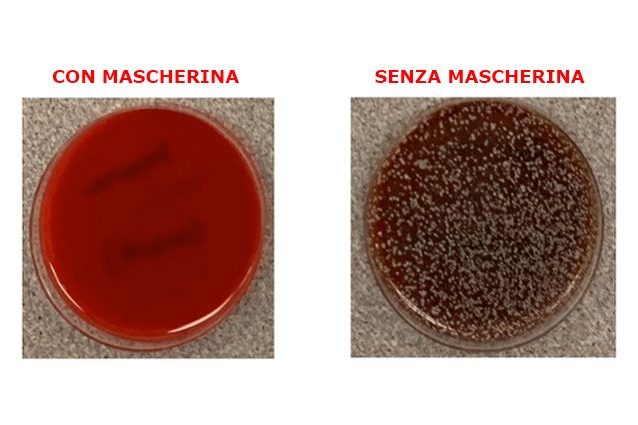

Il professor Richard Davis, direttore del laboratorio di microbiologia clinica presso il Providence Sacred Heart Medical Center di Spokane (Washington), ha realizzato un semplice ma elegante esperimento che mostra come le mascherine riescono a bloccare efficacemente le goccioline che espelliamo mentre tossiamo, starnutiamo e parliamo.
Continua a leggere
